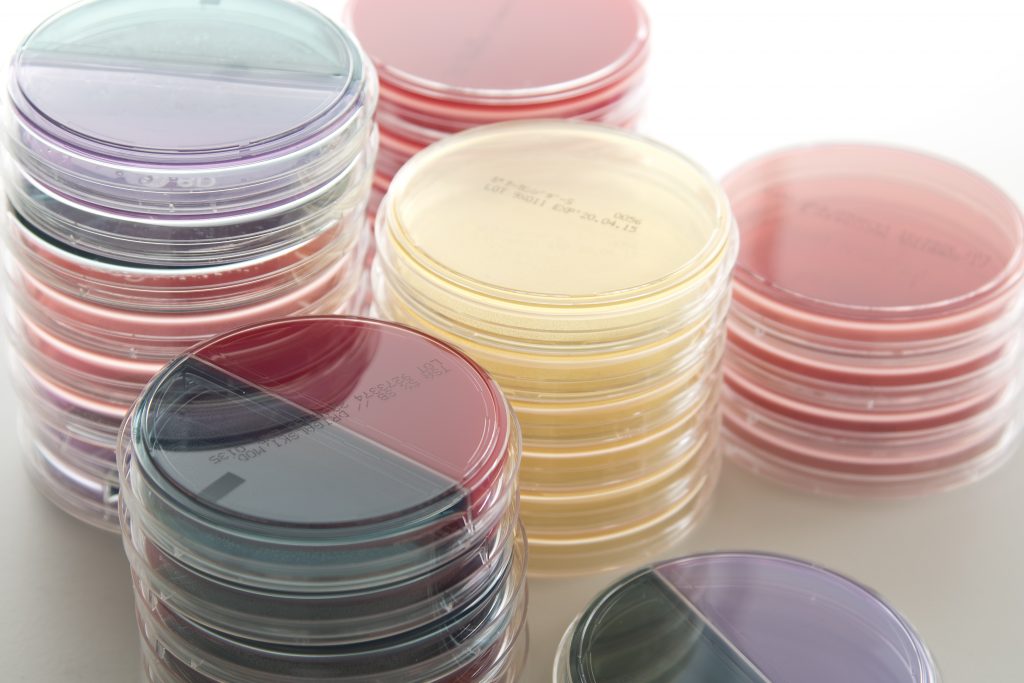

現在、医療における病気の診断、経過観察、治療効果の判定などにおいて、臨床検査はきわめて重要な役割を果たしています。
臨床検査は客観的に病気の容態をとらえるもので、診断・治療に欠かすことのできない手段となっています。
臨床検査の種類には、大きく分けて検体検査と生体検査の二つがあります。
検体検査は、患者さんから採取される材料(検体)を対象とした検査をいいます。
よく用いられる材料には、血液、尿、便があり、そのほかに分泌液(喀痰・胃液・十二指腸液・精液)や穿刺液(髄液・腹水・胸水・関節液)などもあります。
一方、生体検査は、患者さんの体の機能を調べる検査で「生理検査」とも呼ばれ、循環機能検査(心電図・心音図・心エコー)や呼吸機能検査(肺活量)、脳波、筋電図検査などがあります。
検体検査は、対象となる材料や検査方法の違いによって、尿・糞便等一般検査、生化学的検査、血液学的検査、免疫学的検査、微生物学的検査、病理学的検査、遺伝子検査に分けられます。